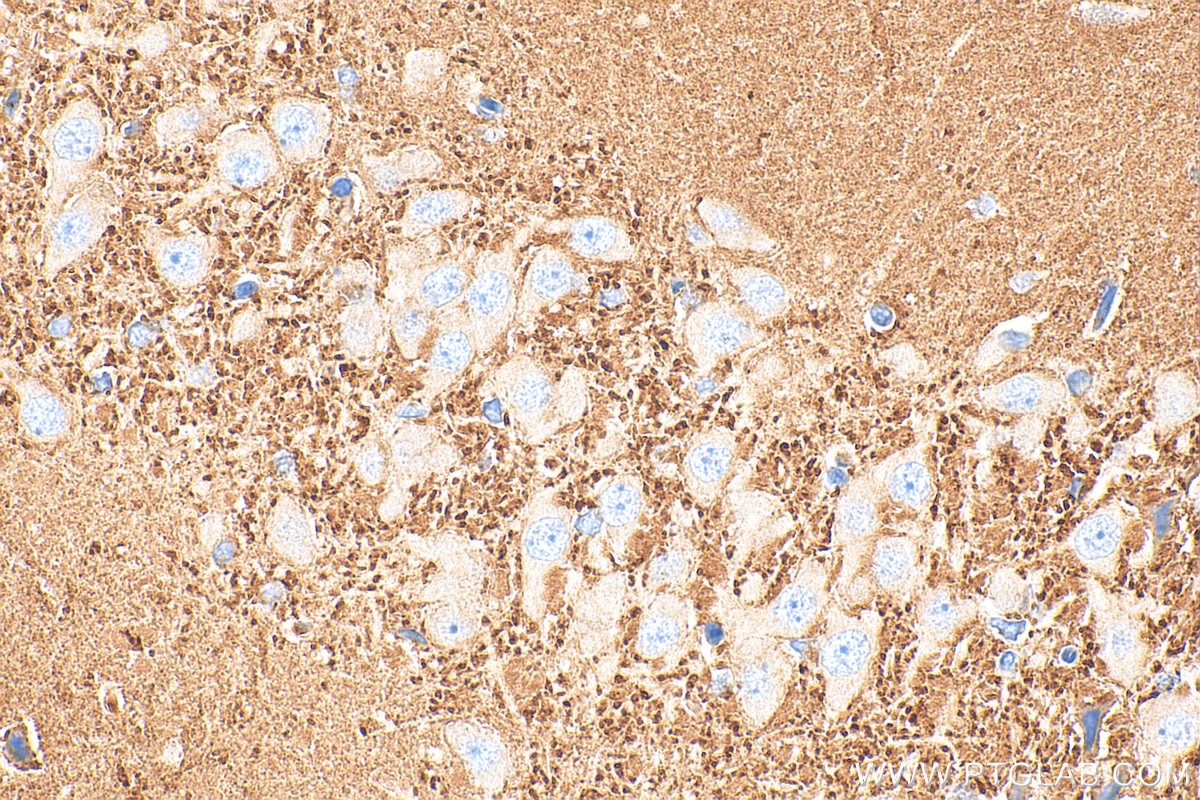
Immunohistochemistry (IHC) staining of rat brain tissue using SYN2 Polyclonal antibody (16573-1-AP)

Tested Applications
| Positive WB detected in | mouse brain tissue, 37°C incubated rat brain tissue |
| Positive IHC detected in | rat brain tissue Note: suggested antigen retrieval with TE buffer pH 9.0; (*) Alternatively, antigen retrieval may be performed with citrate buffer pH 6.0 |
Recommended dilution
| Application | Dilution |
|---|---|
| Western Blot (WB) | WB : 1:5000-1:50000 |
| Immunohistochemistry (IHC) | IHC : 1:300-1:1200 |
| It is recommended that this reagent should be titrated in each testing system to obtain optimal results. | |
| Sample-dependent, Check data in validation data gallery. | |
Published Applications
| WB | See 4 publications below |
Product Information
16573-1-AP targets SYN2 in WB, IHC, ELISA applications and shows reactivity with human, mouse, rat samples.
| Tested Reactivity | human, mouse, rat |
| Cited Reactivity | human, mouse |
| Host / Isotype | Rabbit / IgG |
| Class | Polyclonal |
| Type | Antibody |
| Immunogen |
CatNo: Ag9855 Product name: Recombinant human SYN2 protein Source: e coli.-derived, PGEX-4T Tag: GST Domain: 233-582 aa of BC051307 Sequence: VAIYKTLGGEKFPLIEQTYYPNHKEMLTLPTFPVVVKIGHAHSGMGKVKVENHYDFQDIASVVALTQTYATAEPFIDSKYDIRVQKIGNNYKAYMRTSISGNWKTNTGSAMLEQIAMSDRYKLWVDTCSEMFGGLDICAVKAVHGKDGKDYIFEVMDCSMPLIGEHQVEDRQLITELVISKMNQLLSRTPALSPQRPLTTQQPQSGTLKDPDSSKTPPQRPPPQGGPGQPQGMQPPGKVLPPRRLPPGPSLPPSSSSSSSSSSSAPQRPGGPTAHGDAPSSSSSLAEAQPPLAAPPQKPQPHPQLNKSQSLTNAFSFSESSFFRSSANEDEAKAETIRSLRKSFASLFSD Predict reactive species |
| Full Name | synapsin II |
| Calculated Molecular Weight | 582 aa, 63 kDa |
| Observed Molecular Weight | 70 kDa, 55 kDa |
| GenBank Accession Number | BC051307 |
| Gene Symbol | SYN2 |
| Gene ID (NCBI) | 6854 |
| RRID | AB_2878281 |
| Conjugate | Unconjugated |
| Form | Liquid |
| Purification Method | Antigen affinity purification |
| UNIPROT ID | Q92777 |
| Storage Buffer | PBS with 0.02% sodium azide and 50% glycerol, pH 7.3. |
| Storage Conditions | Store at -20°C. Stable for one year after shipment. Aliquoting is unnecessary for -20oC storage. 20ul sizes contain 0.1% BSA. |
Background Information
Synapsins (synapsin I, II, III) are a family of synaptic vesicle phosphoproteins that have been implicated in the modulation of neurotransmitter release and in synaptogenesis. Synapsin II (SYN2) is composed of two isoforms, synapsin IIa and IIb, , with molecular weights of 55-58 kDa and 70-75 kDa, respectively.
Protocols
| Product Specific Protocols | |
|---|---|
| IHC protocol for SYN2 antibody 16573-1-AP | Download protocol |
| WB protocol for SYN2 antibody 16573-1-AP | Download protocol |
| Standard Protocols | |
|---|---|
| Click here to view our Standard Protocols |
Publications
| Species | Application | Title |
|---|---|---|
Eur J Pharmacol Investigation of rhodamine derivative on behavioral impairment in a double neurotoxin lesion of substantia nigra and locus coeruleus dysfunctional mice | ||
Genes Dis The Traf2 and NcK interacting kinase inhibitor NCB-0846 suppresses seizure activity involving the decrease of GRIA1 | ||
Int Immunopharmacol pNaktide mitigates inflammation-induced neuronal damage and behavioral deficits through the oxidative stress pathway |